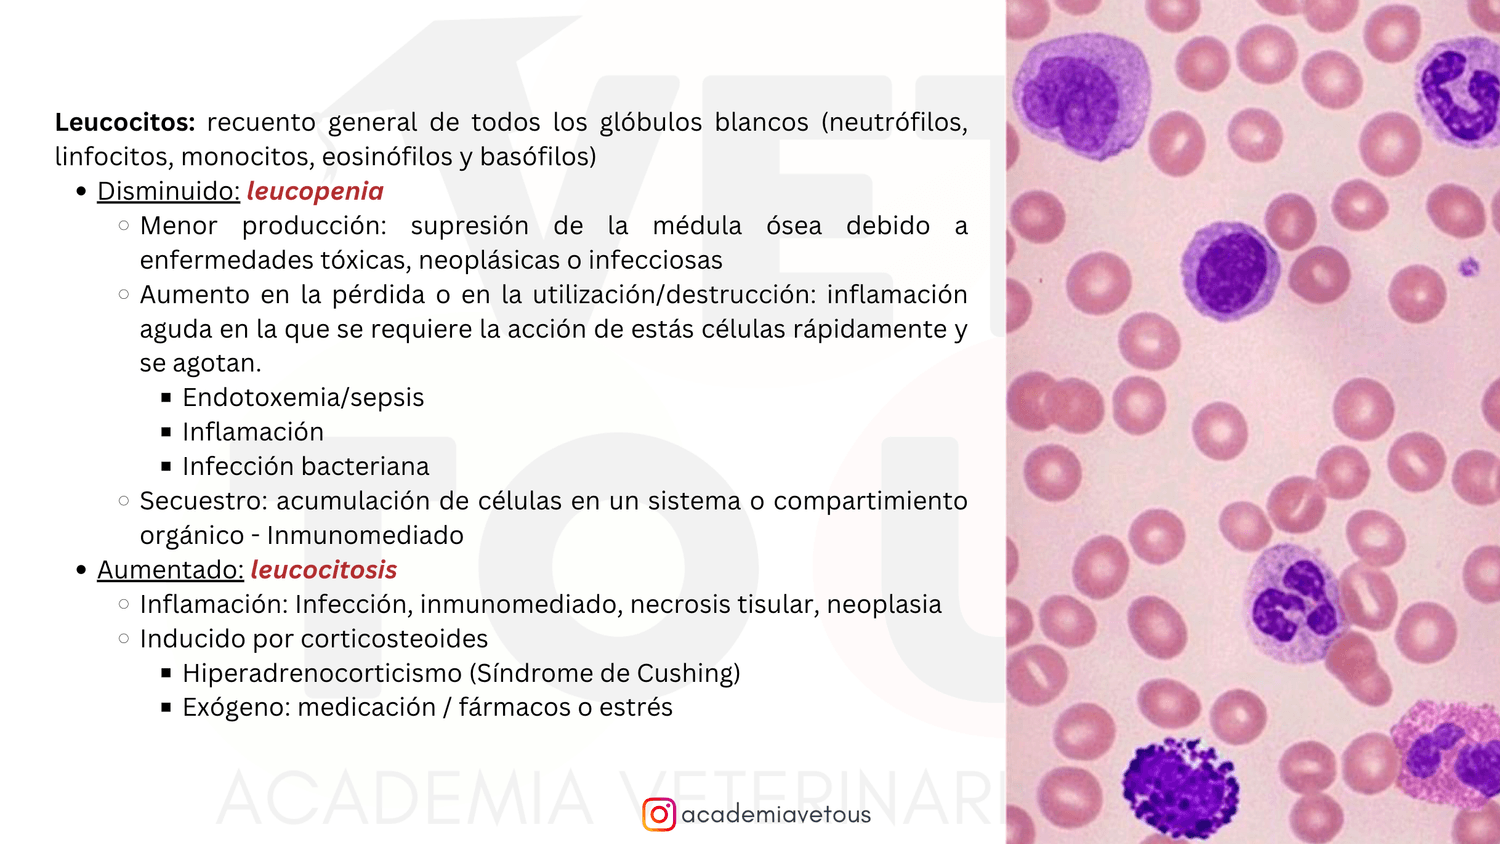

Puedes elegir dos opciones dentro de esta modalidad...
SIN MÓDULO DE CONVENIO VETERINARIO ESTATAL (ESPAÑA)
500€
/ toda la formación
Si realizas un módulo a la semana, estarás formándote 10 semanas con nosotros mínimo.
Ideal para alumnos con poco tiempo que quieren un repaso rápido, práctico y a su ritmo.
Ideal para alumnos no residentes en España.
CON MÓDULO DE CONVENIO VETERINARIO ESTATAL (ESPAÑA)
580€
/ toda la formación
Si realizas un módulo a la semana, estarás formándote 10 semanas con nosotros mínimo.
Ideal para alumnos con poco tiempo que quieren un repaso rápido, práctico y a su ritmo.
Ideal para alumnos que sí residen en España.
🩺 Bases fundamentales para una práctica segura y efectiva.
📚 Adquiere los conocimientos esenciales para ejercer con confianza.
Este programa ha sido diseñado para veterinarios con poca experiencia o que están próximos a incorporarse al entorno laboral. A través de 9 módulos estructurados en diferentes lecciones, desarrollarás una comprensión sólida de los conceptos clave que todo profesional debe manejar con precisión y seguridad desde el inicio de su carrera.
📌 Formación 100% Online.
Accede desde cualquier lugar, sin horarios fijos y a tu propio ritmo.
🇪🇸 Disponible para alumnos que no residan en España.
Los conocimientos fundamentales de la práctica veterinaria son esenciales en cualquier país. Este programa está diseñado para proporcionarte las bases imprescindibles que necesitas para comenzar a trabajar con seguridad, independientemente de dónde te encuentres.
💳 Facilidades de pago internacionales: Aceptamos diversas plataformas de pago que simplifican el proceso, garantizando conversiones de moneda automáticas y seguras.
🎯 ¿Qué incluye este programa?
Nueve módulos estructurados, diseñados para un aprendizaje progresivo y efectivo. Organizados de manera progresiva para facilitar el aprendizaje. Cada módulo está compuesto por varias lecciones diseñadas para asimilar los conocimientos de forma clara y efectiva. Cada lección incluye:
📽 Sesión en vídeo grabada, que podrás ver tantas veces como necesites. Podrás pausarla para hacerte tus propios apuntes, esquemas y protocolos.
📑 Presentaciones con imágenes, diagramas y protocolos, que facilitan la comprensión de los conceptos clave.
📋 Ejercicios prácticos online, diseñados para aplicar la teoría a situaciones reales: elaboración de protocolos clínicos, visualización de procedimientos veterinarios reales, exámenes y autoevaluaciones para reforzar conocimientos, cálculo de dosis y planificación terapéutica...
⚕ Formación basada en casos clínicos reales, con un enfoque práctico y aplicado a la realidad profesional.

📚 Contenido por módulos
📂 Módulo 01: Cómo empezar a pasar consulta. Anamnesis, examen físico general, examen físico ortopédico y examen físico neurológico.
📂 Módulo 02: Interpretación del hemograma. Anemias, clasificación e interpertración de la serie blanca.
📂 Módulo 03: Bioquímica general, ionograma y otros parámetros importantes. Anexo sobre la enfermedad renal crónica y su clasificación.
📂 Módulo 04: Convenio Colectivo Veterinario, conoce tus condiciones laborales para poder exigir un comienzo laboral correcto. Cómo interpretar la nómina, entendiendo lo que cobras. - Posibilidad de añadir/eliminar este módulo, recomendable para residentes en España.
📂 Módulo 05: Protocolo de vacunación y desparasitación correcto en perro y gato.
📂 Módulo 06: Hospitalización y fluidoterapia. Suplementación de la fluidoterapia. Cómo hacer una CRI.
📂 Módulo 07: Farmacología general. Cómo hacer recetas correctamente.
📂 Módulo 08: Las urgencias no dan miedo. Triaje en urgencias y monitorización correcta en pacientes de urgencias.
📂 Módulo 09: Anestesia y sedación. Intubación en perro y gato.
📂 Módulo 10: Eutanasia, la gran olvidada. Aprende lo importante para saber hacer lo correcto en situaciones complicadas.
👩⚕️ ¿A quién está dirigido?
👉 Estudiantes de últimos años de universidad que quieren llegar preparados a su primer trabajo, sin lagunas ni inseguridades.
👉 Veterinarios en sus primeros pasos profesionales, que necesitan una base sólida para desenvolverse con seguridad en la clínica.
👉 Profesionales con poca experiencia, que buscan reforzar conocimientos fundamentales y eliminar dudas en conceptos clave.
👉 Quienes sienten inseguridad en la práctica diaria y desean afianzar las bases antes de enfrentarse a casos más complejos.
👉 Veterinarios que prefieren una formación flexible, sin horarios, para estudiar a su ritmo desde cualquier parte del mundo.
👉 Aquellos que quieren trabajar desde la base, repasando aspectos esenciales que a menudo se dan por sabidos, pero que pueden generar dudas y frustración si no se dominan correctamente.
👉 Personas que buscan no solo aprender, sino aplicar, creando sus propios apuntes y protocolos, y fortaleciendo su criterio clínico desde el principio.
¿Todavía tienes dudas de si esta formación es lo que necesitas?
Si estás empezando en el mundo laboral como veterinario o tienes poca experiencia, es normal preguntarse qué camino seguir. Para ayudarte, ofrecemos una videollamada de asesoramiento gratuita, donde analizaremos tu situación y te recomendaremos la mejor opción para ti.
Evaluaremos tu caso de manera personalizada
Resolveremos tus dudas sobre nuestras formaciones
Te guiaremos para que tomes la mejor decisión según tus objetivos
Te explicaremos en qué consiste la formación y resolveremos las dudas que te hayan podido surgir.
📌 Antes de la llamada, solo te pedimos que rellenes un breve cuestionario para conocerte mejor y asegurarnos de que la sesión sea lo más útil posible.
📅 El siguiente paso es reservar tu videollamada de asesoramiento gratuito en el horario que mejor te convenga. En esta sesión, evaluaremos tu situación y te guiaremos para encontrar la formación que mejor se adapte a tus necesidades.
Agradecemos tu compromiso con la sesión.
Dado que reservamos un espacio exclusivo para ti, te pedimos que asistas puntualmente. Si por algún motivo no puedes asistir, es fundamental que reprogrames con suficiente antelación o nos contactes por WhatsApp para informarnos.
Esto nos permite optimizar nuestro tiempo y seguir ofreciendo asesoramiento personalizado a quienes lo necesitan.